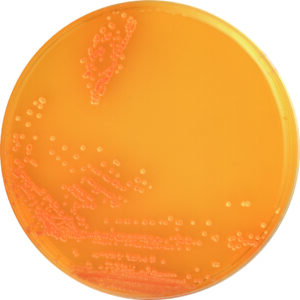
Candida GE Agar

Products
Showing 76–90 of 214 results
-
Bio-Shield Total 5
-
Bio-Shield Total ES
-
Bio-Shield Total OP
-
Bio-Shield ZON
-
Bio-Shield ZON 5
-
BioQuick-Beta-lactam+ Cefalexin+Tetracyclines
-
BioQuick-Beta-lactams
-
BioQuick-Beta-lactams + Streptomycin+ Chloramphenicol+ Tetracyclines
-
BioQuick-Beta-lactams + Tetracyclines
-
Biotin Assay Medium
-
BioTrac 4250
-
BL Agar
-
Buffer Peptone Water
-
Candida GE Agar
-
Carbaryl